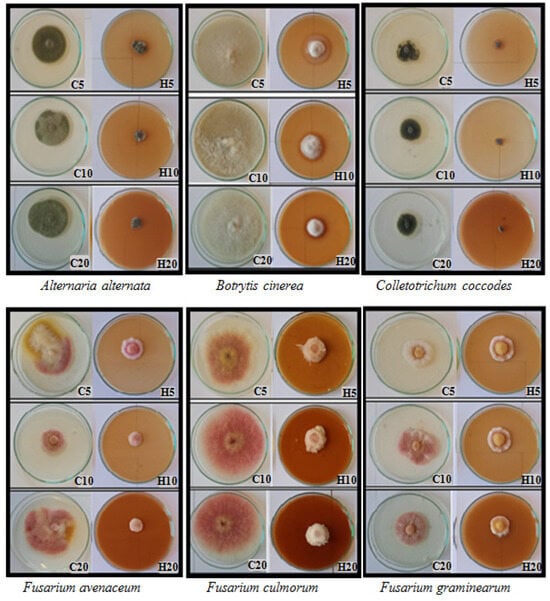

Abstract
The primary objective of this investigation was to assess the potential applicability of hemp (Cannabis sativa L. var. sativa) lateral inflorescence extract in mitigating the growth of fungi, including phytopathogens, on agricultural plants. The extract, comprising a blend of biologically active compounds, holds promise for integration into contemporary plant protection methodologies. The research involved a comprehensive analysis of the extract’s chemical composition, encompassing the determination of total polyphenol and flavonoid content (utilizing spectrophotometric methods), antioxidant activity (evaluated through the DPPH method employing synthetic 2,2-diphenyl-1-picrylhydrazyl radical), and cannabinoid content (analyzed using HPLC techniques). Additionally, this study employed the poisoned substrate method to gauge the impact of 5, 10, and 20% extract concentrations on the growth of various microfungi, including Alternaria alternata, Botrytis cinerea, Colletotrichum coccodes, Fusarium avenaceum, F. culmorum, F. graminearum, F. oxysporum, F. sporotrichioides, and Trichoderma koningii. The hemp extract demonstrated a substantial presence of total polyphenolic compounds, with polyphenol and flavonoid concentrations measuring 149.65 mg/mL and 1.55 mg/mL, respectively. Furthermore, the extract contained cannabinoids at a concentration of 0.12%. The most pronounced antifungal activity was observed with the 20% extract, particularly against T. koningii (62.22–84.79%), C. coccodes (61.65–81.82%), and B. cinerea (45.00–75.42%). However, the efficacy of hemp extracts exhibited large differences against Fusarium spp. (3.10–72.95%), dependent on the specific extract and fungus strain. Introduction of hemp extracts to the substrate induced a reduction in substrate pigment and a discernible color alteration in the mycelium to a lighter shade compared to the control. These findings mark the initial phase in the exploration of practical applications for plant extracts, setting the groundwork for subsequent field trials to ascertain the extract’s impact on phytotoxicity and the health status of agricultural plants.
1. Introduction
Intensive agriculture has been linked to severe environmental repercussions, primarily attributable to the excessive utilization of agricultural chemicals, a notable source of pollution. The overapplication of pesticides contributes to heightened pest resistance, posing challenges for effective pest control [1]. Consequently, there is a continuous quest for innovative and safe approaches to enhance plant growth and stress resistance [2]. This circumstance instigates exploration into novel technologies and production methods that can yield economically profitable harvests while ensuring environmental protection. An approach aligned with these requirements is integrated plant protection, emphasizing the sustainable use of pesticides, with a preference for non-chemical methods, notably those derived from natural sources. This strategy necessitates a discerning selection of preparations, particularly considering the phased withdrawal of active pesticide ingredients [3]. In line with the European Union’s Green Deal initiative, the gradual reduction in synthetic products in favor of natural alternatives, including phytochemicals, is endorsed.
Phytochemicals, recognized for their roles in the pharmaceutical industry, also hold significance in agriculture and veterinary practices [4]. Suteu et al. [5] affirmed the viability of replacing chemical plant protection agents with biologicals, especially in smaller farms and for seed and grain storage. Biopesticides, a subset of biological agents, encompass natural preparations primarily derived from plants and microorganisms (microalgae, viruses, antagonistic fungi, and bacteria) and are applied to manage agricultural pests and pathogens [6]. Currently, biopesticides stand as a pivotal component in integrated crop protection programs, offering a natural alternative to chemical pesticides [7]. Among the three main groups of biopesticides, those based on biologically active compounds from plants, including extracts and essential oils, are prominent [6,8]. Plants, by virtue of harboring bioactive chemical compounds with biocidal effects, notably cannabinoids, terpenes, and phenolic compounds, offer substantial prospects for ensuring the protection and safety of food [9]. The in-depth investigation into the biochemistry of hemp seed (Cannabis sativa L.) has laid the groundwork for a comprehensive exploration of the chemistry, biology, and medicinal attributes inherent in this plant [10]. The genus Cannabis L. stands as a monotypic taxon, signifying it encompasses only one species—Cannabis sativa L. (hemp). This species has undergone subdivision into two subspecies distinguished by their THC (tetrahydrocannabinol) content. C. sativa L. var. sativa manifests a low level of Δ9-THC, while C. sativa L. var. indica is characterized by elevated levels of Δ9-THC (25–30%) [11,12,13,14]. Hemp, being a versatile industrial species, emerges as a prolific source of phytochemicals, boasting descriptions of over 560 biologically active compounds [10,15,16]. These compounds delineate hemp’s multifaceted properties, encompassing antimicrobial, antiparasitic, anti-inflammatory, antioxidant, analgesic, and anticancer attributes [17,18].
The objective of the research was to analyze the chemical composition of hemp inflorescence extracts as well as to evaluate their fungistatic activity against selected fungi affecting agricultural plants. The antifungal effect was assessed by calculating the linear growth inhibition coefficient of the fungi. The obtained results will allow for the assessment of the degree of fungistatic effect of hemp extracts against the tested groups of pathogens. In addition, the concentration of hemp extract that most effectively inhibits fungal growth will be determined. The information obtained will be used for further research, focusing on improving the composition and recipe of the hemp-based product, and then field assessing its effectiveness as a product used in plant protection.
2. Materials and Methods
2.1. Pant Material
The botanical specimens comprised lateral inflorescences obtained from hemp (Cannabis sativa L. var. sativa) of the ‘Futura 75’ variety, cultivated in the Lublin region (51°15′00″ N, 22°34′00″ E). Following harvesting, the plant matter underwent desiccation in a shaded and well-ventilated environment, at a standard room temperature of 22 °C, followed by meticulous grinding. The moisture levels in the desiccated material were ascertained using a WPS 50 SX moisture analyzer (RADWAG, Radom, Poland), ensuring that the plant material achieved a moisture content not exceeding 9%. The raw materials were subsequently securely stored in hermetic packaging, shielded from direct light and moisture.
2.2. Extract Preparation
Hemp extracts (H) were formulated by suspending 100 g of finely crushed plant material (lateral inflorescences) in 1000 mL of 70% ethanol, employing a methodology described by Kursa et al. [19]. The extraction process transpired under a reflux condenser, maintaining the ethanol at its boiling point, spanning a duration of 6 h. The resultant extract underwent filtration via filter paper and subsequent concentration to 100 mL (1:1 extract) through the utilization of a rotary evaporator (Heidolph Instruments, Schwabach, Germany). Filtrak Qualitative Folded Filters (Grade 6, 80 g·m−2, Sartorius, Göttingen, Germany) were employed for the filtration of the extracts. The final extract was diligently preserved at a low temperature of 4 °C.
2.3. Characteristics of the Chemical Composition of Hemp Extracts and Analysis of Their Antioxidant Activity
The quantitative analysis of hemp extracts (1:1) encompassed the assessment of total polyphenols, total flavonoids, cannabinoid content, and antioxidant activity.
2.3.1. Evaluation of Total Polyphenol Content
Polyphenol content in hemp extracts was determined using a modified method based on Singleton and Rossi, employing spectrophotometry (λ = 765 nm) with the Folin–Ciocalteau reagent, as outlined by Singleton and Rossi [19,20]. The quantification of polyphenols (expressed as gallic acid equivalents) relied on the calibration curve established for gallic acid as a standard, within the concentration range of 10–100 mg·L−1 (10, 20, 40, 60, 80, 100 mg·L−1). Samples were appropriately diluted to align with their initial concentrations as per the standard curve. All analyses were performed in triplicate.
2.3.2. Evaluation of Flavonoid Content
The determination of total flavonoid content in hemp extracts followed a modified method by Karadeniz and coauthors [21] employing spectrophotometry (λ = 510 nm) [19]. Results, expressed as epicatechin equivalents, were derived from a calibration curve established using epicatechin standards within the concentration range of 10 to 400 mg·L−1 (10, 50, 100, 150, 200, 250, 300, 350, and 400 mg·L−1). To achieve target extract concentrations (5, 10, and 20%), 50 g, 100 g, and 200 g of the crude concentrated extract (1:1) were, respectively, weighed and adjusted with distilled water to a final weight of 1000 g. The aforementioned analyses were conducted in triplicate.
2.3.3. Estimation of Cannabinoid Content
Chromatographic analysis of cannabinoids was conducted following a modified procedure by Mandrioli et al. [22]. The commercial product “Ultra Extract,” containing 20% CBD hemp oil (Kropla CBD, Bartosz Michalski, Lublin, Poland), obtained through supercritical CO2 extraction, served as a reference for the qualitative comparison of the experimental extract. Standard mixtures of cannabinoids, including cannabidiol (CBD), cannabidiolic acid (CBDA), ∆9-tetrahydrocannabinol (∆9-THC), cannabigerol (CBG), cannabichromene (CBC), cannabidivarin (CBDV), cannabinol (CBN), cannabigerolic acid (CBGA), and tetrahydrocannabivarin (THCV), were appropriately diluted in acetonitrile for eight points within the concentration range of 0.05 to 100 mL−1 (0.05, 0.50, 4.17, 8.33, 16.70, 25.00, 50.00, and 100.00 µg·mL−1). These standard solutions were stored away from light at a temperature of 20 °C. The reference sample was diluted with a methanol and water mixture to a concentration of 0.025 mg/mL, based on the CBD content declared by the manufacturer, while the experimental extract sample remained undiluted. Subsequently, using a syringe filter with a diameter of 0.45 µm, extract samples were filtered into glass vials. The separation and quantification of cannabinoids were performed using a Thermo-Scientific UltiMate 3000 HPLC system.
HPLC analysis conditions:
- -
- RP C18 Nex-Leaf CBX Potency 150 × 4.6 mm, 2.7 μm column with Nex-Leaf CBX 5 × 4.6 mm, 2.7 μm precolumn.
- -
- Gradient elution: water + 0.085% phosphoric acid (A), acetonitrile + 0.085% phosphoric acid (B); 70% B until 3 min, 85% B until 7 min, 95% B from 7.01 min to 8.00 min, then 70% B until 10 min.
- -
- Mobile phase flow rate 1.0 mL/min.
- -
- Chromatographic column temperature 35 °C.
- -
- Injection volume 5 µL.
- -
- Detection at λ = 220 nm
- -
- Analysis time 8 min.
A qualitative analysis was performed, considering the retention times of the individual peaks of the standards. Quantitative analysis involved determining the areas of the identified cannabinoids’ individual peaks and correlating these values with the established equations of the calibration curves for each standard.
2.3.4. Assessment of Antioxidant Activity
The antioxidant activity of hemp extracts, expressed in mM Trolox, was evaluated using a modified procedure outlined by Brand-Williams et al. [23], employing the synthetic radical 1,1-diphenyl-2-picrylhydrazyl (DPPH, Sigma) [24]. The antioxidant’s capability to counteract the oxidation reaction was calculated using the following formula: % inhibition = 100 (A0 − Am)/A0, where Am is the mean absorbance of the test solution containing antioxidant, and A0 is the absorbance of DPPH radical solution.
2.4. Biological Tests
2.4.1. Preparation of Fungal Cultures
The strains of fungi used in the experiment were obtained in the years 2020–2021 as a result of mycological analysis of grains of Triticum aestivum L., varieties: ‘Linus’ (RAGT Semences Group, Rodez, France), ‘Euforia’ (Station of Plant Breeding in Strzelce, Poland), ‘Hondia’ (Przedsiębiorstwo Hodowli Roślin DANKO, Choryni, Poland), and tomato seeds (Lycopersicon esculentum L.) of the variety ‘Alka’ (W. Legutko Przedsiębiorstwo Hodowlano-Nasienne Sp. z o.o., Jutrosin, Poland). The following fungal species were included in the in vitro tests: Alternaria alternata (strain PCL10), Botrytis cinerea (strain CH10), Colletotrichum coccodes (Wallr.) (strain P74/2), Fusarium avenaceum (strain P27), Fusarium culmorum (strain Fc37), Fusarium graminearum (strain Fg54), Fusarium oxysporum (strain ECR4), Fusarium sporotrichioides (strain P41) and Trichoderma koningii (strain K4/11/20).
Fungal colonies originated from 10-day-old single-spore colonies inoculated on potato-dextrose agar (PDA, Difco) sourced from the microorganisms collection of the University of Life Sciences in Lublin, Plant Protection Department. Confirmation of the affiliation of the fungal strain to the species was made on the basis of microscopic analysis of each isolate/strain (structure and size of spores, colony colour) using appropriate mycological keys. In order to confirm the species affiliation of the tested Fusarium spp., as fungi with high morphological variability, the molecular BIO-PCR method was additionally used, using SCARs (Sequence Characterized Amplified Regions) markers [25]. Currently, the above-mentioned markers remain already developed for most species of the genus Fusarium, important from an economic point of view. Markers have been developed, among others, for: F. avenaceum [26], F. culmorum [27,28], F. graminearum [27,28], and F. oxysporum [29].
2.4.2. Assessment of Antifungal Extract Activity—In Vitro Tests
The study assessed the impact of 5, 10, and 20% hemp inflorescence extracts (H) on the growth of the examined microfungi using the poisoned substrate method [30]. The control sample comprised fungal colonies with the addition of 5, 10, and 20% of the residue of the evaporated extraction solvent (70% ethanol) introduced to the PDA microbiological medium. The experiment was replicated five times for each research combination, and the experimental combinations were stored at 25 °C for 10 days. Measurements of fungal colony diameter (mm) were conducted on 2, 4, 6, 8, and 10 days. The inhibition of mycelial growth on the culture medium supplemented with hemp extract, in comparison to the control combination, served as an indicator of the antifungal effect of the extract. The antifungal effect of hemp extracts was quantified using the stimulation/inhibition coefficient of fungal colony growth calculated according to Abbott’s formula [30]. Changes in the color, structure, and morphology of the fungi were observed on day 6 of the experiment using an MB5 optical microscope (Opta-Tech, Warsaw, Poland).
2.5. Statistical Analysis
Data were analyzed by one-way analysis of variance (test of Duncan) at a significance level of p ≤ 0.05 using Statistica 12.6 software (StatSoft Poland, Krakow, Poland). All phytochemical analyses were performed in triplicate, while microbiological tests were performed in five repetitions for each experimental combination.
3. Results
3.1. Content of Selected Biologically Active Substances in the Extract
The total flavonoid content (expressed as epicatechin equivalents) in the hemp extract (100%, 1:1) was determined to be 1.55 mg·mL−1, whereas the polyphenol content (calculated as gallic acid equivalents) in the analyzed extract measured 149.65 mg·mL−1 (Table 1). Additionally, the antioxidant activity, represented as a percentage of inhibition, reached 22.93%, equivalent to 32.05 mM Trolox.
Table 1.
Content of flavonoids (epicatechin equivalent mg/mL), polyphenols (gallic acid equivalent mg/mL) and antioxidant activity in the basal extract from hemp inflorescensces (100%, 1:1).
Table 2 shows the characteristics of hemp extracts in terms of cannabinoid content compared to a commercial product, i.e., CBD hemp oil 20% “Ultra Extract”.
Table 2.
Cannabinoid content of the experimental hemp seed extract compared to the reference extract (commercial product: hemp oil CBD 20% “Ultra Extract”).
In the experimental extract, the presence of cannabidiol (CBD) was identified at a concentration of 0.08%, and cannabidiolic acid (CBDA) at 0.04%. These concentrations were notably lower than those observed in the reference sample, where CBD and CBDA levels were 20.71% and 1.10%, respectively. The disparity can be attributed to the utilization of supercritical CO2 in the commercial preparation, favoring the extraction of biologically active compounds with a higher affinity for cannabinoids. Furthermore, the analysis confirmed the existence of Δ9-THC (0.11%), CBC (0.22%), CBGA (0.06%), CBG (2.66%), CBDV (0.08%), and CBN (0.02%) in the commercial product. The conventional extraction methods for these components involve solvents with a high affinity for cannabinoids, such as ethanol, methanol, or hexane, and supercritical CO2, while water, as used in this experiment, exhibits low affinity [31,32]. The 70% ethanol employed in the experiment was subsequently evaporated during the extract concentration process, resulting in a water extract.
3.2. Inhibition of Fungal Growth
As a result of plate tests, the direct impact of hemp extracts on the growth dynamics of the tested fungal species was determined. The effect of hemp extract on the growth of the tested fungus strain varied based on the extract concentration and its duration of action. Hemp extracts exhibited the most potent fungistatic activity against Trichoderma koningii, Botrytis cinerea, and Colletotrichum coccodes, while the weakest effect was observed against Fusarium graminearum (Figure 1 and Figure 2, Table 3). The antifungal activity of hemp extracts intensified with higher concentrations, with the most potent effects observed for 20% hemp extracts. The highest activity of the hemp extract was recorded for the H20 concentration against B. cinerea. In the control (C20), the fungus displayed dynamic growth, reaching a diameter of 90 mm on day 8, whereas in the H20 combination, it reached only 37 mm. Similar trends were observed for T. koningii, where in the control (C20) on day 4, the fungus reached a diameter of 87.6 mm, while in the H20 combination, its diameter was only 13.3 mm. Fusarium species exhibited varying growth dynamics depending on the species and the concentration of the extract in the medium. The fastest growth was recorded on day 6 for F. culmorum (C20: 89.3 mm, H20: 24.2 mm) and on day 8 for F. sporotrichioides (C20: 90 mm, H20: 36.5 mm). The remaining Fusarium species grew more slowly, with the diameter of their colonies on the 10th day of the experiment after the addition of the extract being lower than 40 mm (Figure 1).

Figure 1.
Colony diameter (mm) of fungi growing on potato dextrose agar (PDA) with addition of hemp extracts; C5, C10, C20—control with 5, 10, 20% residue of solvent; H5, H10, H20—5, 10, 20% hemp extract concentration.
Figure 2.
Fungal growth on potato dextrose agar (PDA, Difco) with different concentration of hemp extracts; C5, C10, C20—control with 5, 10, 20% residue of solvent; H5, H10, H20—5, 10, 20% hemp extract concentration; day 6 of growth.
Table 3.
Inhibition (%) of growth of fungi (mm) growing on PDA medium with the addition of various concentrations of hemp extract.
Hemp extracts (H) exhibited varying degrees of inhibition against the growth of the tested fungal species, dependent on the fungus species/strain, extract concentration, and experiment duration. The antifungal activity of hemp extracts increased progressively throughout the experiment, with the 20% extract (H20) demonstrating the highest effectiveness, statistically stronger than the effects of the 5% (H5) and 10% (H10) extracts. The superior antifungal effect of the 20% hemp extract was attributed to its higher concentration of biologically active compounds, such as polyphenols, compared to the 5% and 10% hemp extracts. The most potent antifungal activity was observed against T. koningii (H20: 62.22–84.79%), C. coccodes (H20: 61.65–81.82%), and B. cinerea (H20: 45.00–75.42%). The 20% extract significantly inhibited fungal growth compared to its lower concentrations (Figure 1 and Figure 2, Table 3). A substantial antifungal effect of the extracts was also noted against A. alternata, where the antifungal effect of H20 persisted even on day 10 of the experiment, reaching 74.46% (Figure 1, Table 3). Weaker effectiveness of hemp extracts was recorded against Fusarium spp., with the lowest degree of fungal growth inhibition observed for the 5% extract (H5) against F. graminearum (H5: 13.1%) and the highest for the 20% concentration (H20) against F. culmorum (H20: 72.95%). Among the fungi of the genus Fusarium, F. graminearum exhibited slower growth than other Fusarium species; therefore, the percentage inhibition of fungal growth after adding the extract, relative to the control, was lower than in other Fusarium species characterized by more dynamic growth. The highest degree of inhibition of F. graminearum was recorded only at a level of 46.91% at a concentration of 10%, on day 2 of the experiment. In the subsequent days, its antifungal activity decreased (Figure 1 and Figure 2, Table 3).
3.3. Fungal Morphology Changes
Throughout the experiment, changes in fungal morphology were systematically evaluated (Table 4). The most prominent alterations were observed in the color of both the obverse and reverse sides of the colonies. The introduction of hemp extracts into the substrate led to the disappearance of pigment in the medium and a lightening of the mycelium’s color compared to the control. Hemp extracts also induced modifications in the mycelial structure. The mycelium of A. alternata, C. coccodes, and F. oxysporum became denser and flatter compared to the control. Regarding other species (B. cinerea, F. avenaceum, F. culmorum, F. graminearum, F. sporotrichioides, T. koningii), fungal colonies growing on the medium with extracts exhibited increased density but also demonstrated enhanced upward growth (Table 4). Hemp extracts also exerted an effect on the intensity of fungal sporulation. The most significant reduction in the number of spores occurred in T. koningii and A. alternata, where the addition of hemp extracts to the substrate inhibited the sporulation process, resulting in smaller and less developed conidia than in the control (Figure 3). The opposite reaction was recorded for fungi of the genus Fusarium, where hemp extracts contributed to the stimulation of sporulation, which is a common defense mechanism of fungi in response to the presence of toxic substances in the medium (Figure 3). The findings substantiated the fungistatic effect of hemp extracts, underscoring the justification for further research in this domain. Evaluation of the phytotoxic potential of hemp extracts and their influence on plant health warrants verification through field experiments.
Table 4.
Selected morphological features of fungal mycelium growing on PDA medium with the addition of various concentrations of hemp extract (day 6 of the experiment).

Figure 3.
Development of fungal spores on PDA with the addition of hemp extracts; C5, C10, C20—control with 5, 10, 20% solvent residue; H5, H10, H20—5, 10, 20% hemp extract; day 6 of growth.
4. Discussion
Plant extracts, owing to their antimicrobial and antioxidant properties, find a broad spectrum of applications in medicine, food, phytopharmaceutical, and cosmetic industries [33,34,35,36,37,38,39]. The multifaceted effects of plant extracts contribute to numerous scientific research endeavors aimed at their comprehensive examination and utilization for antimicrobial purposes [19,40,41,42]. Currently, Cannabis sativa L. sativa is extensively employed in industry and medicine. Industrial hemp serves as the primary source of cannabinoids (cannabidiol—CBD, tetrahydrocannabinol—THC, cannabichromene—CBC, cannabigerol—CBG, cannabinol—CBN) [43]. Cannabis is a complex and rich plant capable of producing more than 480 molecules. The content of biologically active components and their biocidal activity vary depending on specific parts of hemp, and their mode of action is contingent on the type of substrate used (plant material, alcohol, or water extracts) [44]. Numerous scientific studies have corroborated the effectiveness of selected groups of secondary metabolites with antimicrobial properties found in hemp extracts and their potential for use as alternative biopesticides [45,46].
In addition to being a rich source of biologically active compounds, hemp brings a number of benefits to the environment (carbon dioxide storage, interrupting the cycle of plant diseases in crop rotation, cleansing the soil of weed seeds, preventing soil erosion and increasing biodiversity). Therefore, in recent years, the area under hemp cultivation in the European Union (EU) has increased by 75% and hemp production by 62.4% [47]. Hemp cultivation, apart from providing measurable economic benefits for the producer, also contributes to the achievement of the goals of the European Green Deal. Due to the increase in the area of hemp cultivation, there is a need to manage parts of plants that are not directly used for industrial purposes (small side inflorescences, leaves). These parts of the plant can be a source of plant biomass for the production of extracts (also due to the content of phenolic compounds in hemp), which constitute the basis for the production of biopesticides, which are an alternative to synthetic plant protection products.
In the context of the present experiment, the hemp extract exhibited lower values for total flavonoid contents (1.55 mg·mL−1) and antioxidant activity (22.93% and 32.05 mM Trolox) compared to our previously published data [48] on extracts from various species, including horseradish, common yarrow, tansy, sage, and wormwood (total flavonoid contents ranging from 1.18 to 23.06 mg·mL−1, antioxidant activity from 4.55% to 67.58%, and 3.06 to 102.44 mM Trolox). Nevertheless, the total polyphenol content in the tested hemp extract (149.65 mg·mL−1) surpassed that of previously studied plant extracts (ranging from 20.78 to 81.95 mg·mL−1) [48]. Khoury et al. [49] reported comparable findings, suggesting a moderate antioxidant potential of hemp flower extract (Cannabis sativa L.) compared to other bioactive compounds with antifungal properties found in hemp extracts. Phenolic compounds, terpenes, and cannabinoids constitute intriguing chemical groups of secondary metabolites in hemp [50,51]. Among these, cannabinoids, as monoterpenes with an aryl group resulting from the condensation of terpenes and phenolic compounds [50,52], are particularly noteworthy due to their antimicrobial properties [53]. The content of cannabinoids is influenced by both biotic factors (plant genotype, developmental stage) and abiotic factors (nutrient availability, temperature, light). The highest concentrations of these compounds are typically found in the inflorescences, with lower levels in leaves and stems [54,55,56]. The primary cannabinoid in industrial hemp (fiber-type) is cannabidiol (CBD), lacking the psychoactive properties associated with THC (Δ-9tetrahydrocannabinol). CBD is recognized for its antimicrobial, antioxidant, analgesic, anti-inflammatory, anticonvulsant, and neuroprotective functions [56,57]. The content of cannabinoids in industrial hemp plants varies significantly based on the variety and cultivation location, as evidenced by Mańkowska et al. [57], who reported CBD contents ranging from 0.0254% to 0.814% in six varieties of hemp (Cannabis sativa L.) of European and Asian origin. The conducted research on cannabinoid contents in extracts indicates a relatively low total content in the tested extract (0.12%).
Hong et al. [58] reported the potent activity of Indian hemp against select Gram-positive bacteria (Listeria monocytogenes, Staphylococcus epidermidis, Salmonella newington) and Gram-negative bacteria (Pseudomonas aeruginosa, Helicobacter pylori, Escherichia coli), highlighting the potential use of cannabis-derived molecules in human disease therapies. Additionally, Indian hemp extracts exhibited antifungal potential against foot fungus pathogens (Trichophyton interdigitale and Trichophyton rubrum) as well as Candida albicans [59]. The antifungal attributes of hemp arise not only from the presence of cannabinoids but also from other phenolic compounds, a prevalent group of plant constituents known for their robust antimicrobial properties. Numerous authors have confirmed the biocidal properties of hemp extracts, particularly in the medical field [43,60,61].
While contemporary studies on the antimicrobial properties of hemp are limited, a few have focused on the isolated compounds, especially those with low THC content, and fewer still have delved into the antifungal properties of hemp extracts [57,58,59]. Literature data emphasize the varied effectiveness of plant extracts contingent upon the plant material and the extraction methodology [62,63]. Our research underscores that a 20% hemp extract proves most effective in inhibiting the growth of fungi on plants, including pathogenic species such as B. cinerea, C. coccodes, A. alternata, or Fusarium spp. Comparable studies involving extracts from industrial hemp leaves [64,65] demonstrated the effectiveness of water extracts in inhibiting the growth of A. solani (As) and F. oxysporum (Fo) by 31.01–53.53% (As) and 23.47–47.96% (Fo), depending on the extract concentration. Our study, focusing on extracts from industrial hemp lateral inflorescences, revealed greater efficacy in inhibiting fungal growth compared to leaf extracts. The efficacy reached up to 73.57% for a 10% extract concentration and 76.46% for a 20% extract concentration (in the case of A. alternata). Similarly, high efficacy of hemp inflorescence extracts was observed against F. oxysporum, surpassing that of leaf extracts, as reported by Tapwall et al. [65]. Several studies have indicated the inhibitory effects of hemp extracts on toxigenic fungi like Aspergillus spp. and their mycotoxins [62,63]. Despite their broad-spectrum action, the antifungal and mycotoxin inhibitory effectiveness of hemp extracts has not been extensively explored, especially compared to their antioxidant properties. This study contributes valuable data on the fungistatic action of biodegradable hemp extracts. Further investigations are necessary to confirm their effectiveness under field conditions, evaluate their biological stability, selectivity, phytotoxicity, and explore their potential as a properly formulated mixture of plant extracts, which could exhibit enhanced fungistatic effectiveness. This research represents a crucial step and may serve as a foundation for developing a biofungicide for controlling plant diseases.
5. Conclusions
Innovatively addressing agricultural plant pathogens by harnessing the potential of plant extracts emerges as a captivating paradigm in modern crop protection. The strategic integration of fungicides with diverse non-chemical control methodologies, encompassing agronomic practices and resistant crop varieties, offers a robust framework for effective plant protection management. This approach strategically combats pathogen resistance, emphasizing the utilization of safe, next-generation fungicidal products. Crafting such formulations entails meticulous selection of plant components and precise determination of doses/concentrations to attain the desired fungistatic effect.
The experimental results showed the strongest fungistatic effect of hemp extracts against Alternaria alternata, Colletotrichum coccodes, Fusarium avenaceum and F. culmorum, mainly in the first days of the experiment. The extracts inhibited fungal growth significantly better at higher concentration (20%) compared to lower concentrations. The weakest antifungal effect of hemp extract was recorded only against F. graminearum. It was also shown that the greater fungistatic effect of the extract was dependent on the higher content of secondary metabolites (polyphenols and flavonoids) and their high antioxidant activity.
Continuation of these investigations in vivo is imperative to ascertain the optimal composition and application form of the natural product, addressing challenges associated with potential phytotoxic effects. Effectively marketing novel products and devising efficient disease control strategies without compromising plant productivity are pivotal objectives in the pursuit of sustainable agriculture.
Author Contributions
Conceptualization, A.J. and R.K.; methodology, W.K., A.J. and R.K.; validation, A.J. and R.K.; formal analysis, W.K. and J.W.; investigation, W.K., A.J. and R.K.; resources, R.K.; data curation, W.K. and A.J.; writing—original draft preparation, W.K., A.J. and R.K.; writing—review and editing, A.J., R.K. and J.W.; visualization, W.K. and A.J.; supervision, A.J.; project administration, W.K. and A.J.; funding acquisition, W.K., A.J. and R.K. All authors have read and agreed to the published version of the manuscript.
Funding
This research was supported by projects no. SD/68/RiO/2023, no. SUBB.WOK.19.019. Provided by University of Life Sciences in Lublin, Poland.
Institutional Review Board Statement
Not applicable.
Informed Consent Statement
Not applicable.
Data Availability Statement
The original contributions presented in the study are included in the article, further inquiries can be directed to the corresponding authors.
Conflicts of Interest
The authors declare no conflict of interest.
References
- Rohr, J.R.; Barrett, C.B.; Civitello, D.J.; Craft, M.E.; Delius, B.; DeLeo, G.A.; Hudson, P.J.; Jouanard, N.; Nguyen, K.H.; Ostfeld, R.O.; et al. Emerging human infectious diseases and the links to global food production. Nat. Sustain. 2019, 2, 445–456. [Google Scholar] [CrossRef]
- Pańka, D.; Jeske, M.; Łukanowski, A.; Baturo-Cieśniewska, A.; Prus, P.; Maitah, M.; Maitaha, K.; Malec, K.; Rymarz, D.; Muhire’a, J.D.; et al. Can cold plasma be used for boosting plant growth and plant protection in sustainable plant production? Agronomy 2020, 12, 841. [Google Scholar] [CrossRef]
- Ginter, A. Plant protection within the European Green Deal on the example starch potato cultivation. Prog. Plant Prot. 2022, 62, 208–215. [Google Scholar] [CrossRef]
- Ahmed, M.; Ji, M.; Qin, P.; Gu, Z.; Liu, Y.; Sikandar, A.; Iqbal, M.F.; Javeed, A. Phytochemical screening, total phenolic and flavonoids contents and antioxidant activities of Citrullus colocynthis L. and Cannabis sativa L. Appl. Ecol. Environ. Res. 2019, 17, 6961–6979. [Google Scholar] [CrossRef]
- Suteu, D.; Rusu, L.; Zaharia, C.; Badeanu, M.; Daraban, G.M. Challenge of utilization vegetal extracts as natural plant protection products. Appl. Sci. 2020, 10, 8913. [Google Scholar] [CrossRef]
- Kumar, J.; Ramlal, A.; Mallick, D.; Mishra, V. An overview of some biopesticides and their importance in plant protection for commercial acceptance. Plants 2021, 10, 1185. [Google Scholar] [CrossRef]
- Samada, L.H.; Tambunan, U.S.F. Biopesticides as promising alternatives to chemical pesticides: A review of their current and future status. Online J. Biol. Sci. 2020, 20, 66–76. [Google Scholar] [CrossRef]
- Rajput, V.S.; Jhala, J.; Acharya, V.S. Biopesticides and their mode of action against insect pests: A review. Int. J. Chem. Stud. 2020, 8, 2856–2862. [Google Scholar] [CrossRef]
- Ullah, F.; Ayaz, M.; Sadiq, A.; Ullah, F.; Hussain, I.; Shahid, M.; Yessimbekov, Z.; Adhikari-Devkota, A.; Devkota, H.P. Potential role of plant extracts and phytochemicals against foodborne pathogens. Appl. Sci. 2020, 10, 4597. [Google Scholar] [CrossRef]
- ElSohly, M.A.; Radwan, M.M.; Gul, W.; Chandra, S.; Galal, A. Phytochemistry of Cannabis sativa L. In Phytocannabinoids; Kinghorn, A., Falk, H., Gibbons, S., Kobayashi, J., Eds.; Progress in the Chemistry of Organic Natural Products; Springer: Cham, Switzerland, 2017; Volume 103. [Google Scholar] [CrossRef]
- Strzelczyk, M.; Kaniewski, R. Konopie siewne Cannabis sativa L.—Jeden z najstarszych gatunków roślin użytkowych. Postępy Fitoter. 2021, 22, 53–60. [Google Scholar] [CrossRef]
- Kaniewski, R.; Pniewska, I.; Kubacki, A.; Strzelczyk, M.; Chudy, M.; Oleszak, G. Konopie siewne (Cannabis sativa L.)—Wartościowa roślina użytkowa i lecznicza. Postępy Fitoter. 2017, 18, 139–144. [Google Scholar] [CrossRef]
- Aliferis, K.A.; Bernard-Perron, D. Cannabinomics: Application of metabolomics in Cannabis (Cannabis sativa L.) research and development. Front. Plant Sci. 2020, 11, 554. [Google Scholar] [CrossRef]
- Rupasinghe, H.V.; Davis, A.; Kumar, S.K.; Murray, B.; Zheljazkov, V.D. Industrial hemp (Cannabis sativa subsp. sativa) as an emerging source for value-added functional food ingredients and nutraceuticals. Molecules 2020, 25, 4078. [Google Scholar] [CrossRef]
- Andre, C.M.; Hausman, J.F.; Guerriero, G. Cannabis sativa: The plant of the thousand and one molecules. Front. Plant Sci. 2016, 7, 19. [Google Scholar] [CrossRef]
- Di Sotto, A.; Gullì, M.; Acquaviva, A.; Tacchini, M.; Di Simone, S.C.; Chiavaroli, A.; Recinella, Ł.; Leone, S.; Brunetti, L.; Orlando, G.; et al. Phytochemical and pharmacological profiles of the essential oil from the inflorescences of the Cannabis sativa L. Ind. Crop. Prod. 2022, 183, 114980. [Google Scholar] [CrossRef]
- Perera, P.K.; Diddeniya, J.I.D. In-Vitro and In-Vivo supportive research on medicinal properties of Cannabis sativa: A comprehensive review. J. Ayurvedic Herb. Med. 2022, 8, 40–47. [Google Scholar] [CrossRef]
- Schofs, L.; Sparo, M.D.; Sanchez Bruni, S.F. The antimicrobial effect behind Cannabis sativa. Pharmacol. Res. Perspect. 2021, 9, e00761. [Google Scholar] [CrossRef]
- Kursa, W.; Jamiołkowska, A.; Wyrostek, J.; Kowalski, R. Antifungal Effect of Plant Extracts on the Growth of the Cereal Pathogen Fusarium spp.—An in Vitro Study. Agronomy 2022, 12, 3204. [Google Scholar] [CrossRef]
- Singleton, V.L.; Rossi, J.A. Colorimetry of total phenolics with phosphomolybdic -phosphotungstic acid reagents. Am. J. Enol. Viticult. 1965, 16, 144–158. [Google Scholar] [CrossRef]
- Karadeniz, F.; Burdurlu, H.S.; Koca, N.; Soyer, Y. Antioxidant activity of selected fruits and vegetables grown in Turkey. Turk. J. Agric. For. 2005, 29, 297–303. [Google Scholar]
- Mandrioli, M.; Tura, M.; Scotti, S.; Gallina Toschi, T. Fast Detection of 10 Cannabinoids by RP-HPLC-UV Method in Cannabis sativa L. Molecules 2019, 24, 2113. [Google Scholar] [CrossRef] [PubMed]
- Brand-Williams, W.; Cuvelier, M.E.; Berset, C. Use of a Free Radical Method to Evaluate Antioxidant Activity. LWT-Food Sci. Technol. 1995, 28, 25–30. [Google Scholar] [CrossRef]
- Wyrostek, J.; Kowalski, R. Effect of ultrasound and fragmentation of the raw material on the extraction of phenolic compounds from peppermint leaves and black tea. Przemysł Chem. 2022, 101, 928–933. [Google Scholar]
- Kulik, T.; Fordoński, G.; Pszczółkowska, A.; Płodzień, K.; Olszewski, J. Identification of some Fusarium species from selected crop seeds using traditional method and BIO-PCR. Acta Agrobot. 2005, 58, 33–54. [Google Scholar] [CrossRef]
- Turner, A.S.; Lees, A.K.; Rezanoor, H.N.; Nicholson, P. Refinement of PCR-detection of Fusarium avenaceum and evidence from DNA marker studies for phenetic relatedness to Fusarium tricinctum. Plant Pathol. 1998, 47, 278–288. [Google Scholar] [CrossRef]
- Schilling, A.G.; Möller, E.M.; Geiger, H.H. Polymerase Chain Reaction—Based Assays for Species—Specific Detection of Fusarium culmorum, F. graminearum, and F. avenaceum. Phytopathology 1996, 86, 515–523. [Google Scholar] [CrossRef]
- Nicholson, P.; Simpson, D.R.; Weston, G.; Rezanoor, H.N.; Lees, A.K.; Parry, D.W.; Joyce, D. Detection and quantification of Fusarium culmorum and Fusarium graminearum in cereals using PCR assays. Physiol. Molec. Plant Pathol. 1998, 53, 17–37. [Google Scholar] [CrossRef]
- Edel, V.; Steinberg, C.N.; Gautheron, N.; Alabouvette, C. Ribosomal DNA-targeted oligonucleotide probe and PCR assay specific for Fusarium oxysporum. Mycol. Res. 2000, 104, 518–526. [Google Scholar] [CrossRef]
- Jamiołkowska, A.; Kowalski, R. Laboratory effect of Silphium perfoliatum L. on the growth of tested fungi. Acta Sci. Pol.-Hortoru. 2012, 11, 43–55. [Google Scholar]
- Szalata, M.; Dreger, M.; Zielińska, A.; Banach, J.; Szalata, M.; Wielgus, K. Simple Extraction of Cannabinoids from Female Inflorescences of Hemp (Cannabis sativa L.). Molecules 2022, 27, 5868. [Google Scholar] [CrossRef]
- Qamar, S.; Torres, Y.J.M.; Parekh, H.S.; Falconer, J.R. Effects of Ethanol on the Supercritical Carbon Dioxide Extraction of Cannabinoids from Near Equimolar (THC and CBD Balanced) Cannabis Flower. Separations 2021, 8, 154. [Google Scholar] [CrossRef]
- Munekata, P.E.S.; Rocchetti, G.; Pateiro, M.; Lucini, L.; Domínguez, R.; Lorenzo, J.M. Addition of plant extracts to meat and meat products to extend shelf-life and health-promoting attributes: An overview. Curr. Opin. Food Sci. 2020, 31, 81–87. [Google Scholar] [CrossRef]
- Efenberger-Szmechtyk, M.; Nowak, A.; Czyżowska, A. Extracts rich in polyphenols—Natural preservatives of meat products. Przemysł Spożywczy 2018, 72, 28–33. [Google Scholar]
- Hoang, H.T.; Moon, J.Y.; Lee, Y.C. Natural antioxidants from plant extracts in skincare cosmetics: Recent applications. challenges and perspectives. Cosmetics 2021, 8, 106. [Google Scholar] [CrossRef]
- Lacatusu, I.; Istrati, D.; Bordei, N.; Popescu, M.; Seciu, A.M.; Panteli, L.M.; Badea, N. Synergism of plant extract and vegetable oils-based lipid nanocarriers: Emerging trends in development of advanced cosmetic prototype products. Mater. Sci. Eng. C 2020, 108, 110412. [Google Scholar] [CrossRef] [PubMed]
- Harhaun, R.; Kunik, O.; Saribekova, D.; Lazzara, G. Biologically active properties of plant extracts in cosmetic emulsions. Microchem. J. 2020, 154, 104543. [Google Scholar] [CrossRef]
- Veiga, M.; Costa, E.M.; Silva, S.; Pintado, M. Impact of plant extracts upon human health: A review. Crit. Rev. Food Sci. Nutr. 2020, 60, 873–886. [Google Scholar] [CrossRef] [PubMed]
- Rolnik, A.; Olas, B. The plants of the Asteraceae family as agents in the protection of human health. Int. J. Mol. Sci. 2021, 22, 3009. [Google Scholar] [CrossRef]
- Gedikoğlu, A.; Sökmen, M.; Çivit, A. Evaluation of Thymus vulgaris and Thymbra spicata essential oils and plant extracts for chemical composition antioxidant and antimicrobial properties. Food Sci. Nutr. 2019, 7, 1704–1714. [Google Scholar] [CrossRef]
- Behiry, S.I.; Hamad, N.A.; Alotibi, F.O.; Al-Askar, A.A.; Arishi, A.A.; Kenawy, A.M.; Elsamra, I.A.; Youssef, N.H.; Elsharkawy, M.M.; Abdelkhalek, A.; et al. Antifungal and Antiaflatoxigenic Activities of Different Plant Extracts against Aspergillus flavus. Sustainability 2022, 14, 12908. [Google Scholar] [CrossRef]
- Sánchez-Hernández, E.; González-García, V.; Correa-Guimarães, A.; Casanova-Gascón, J.; Martín-Gil, J.; Martín-Ramos, P. Phytochemical profile and activity against Fusarium species of Tamarix gallica bark aqueous ammonia extract. Agronomy 2023, 13, 496. [Google Scholar] [CrossRef]
- Gildea, L.; Ayariga, J.A.; Ajayi, O.S.; Xu, J.; Villafane, R.; Samuel-Foo, M. Cannabis sativa CBD Extract Shows Promising Antibacterial Activity against Salmonella typhimurium and S. newington. Molecules 2022, 27, 2669. [Google Scholar] [CrossRef]
- Audu, B.S.; Ofojekwu, P.C.; Ujah, A.; Ajima, M.N.O. Phytochemical. proximate composition. amino acid profile and characterization of Marijuana (Cannabis sativa L.). J. Phytopharm. 2014, 3, 35–43. [Google Scholar] [CrossRef]
- Adaszyńska, M.; Swarcewicz, M. Olejki eteryczne jako substancje aktywne lub konserwanty w kosmetykach. Wiadomości Chem. 2012, 66, 139–158. [Google Scholar]
- Haliński, Ł. Metabolity wtórne roślin jako alternatywne pestycydy. Lab.-Przegląd Ogólnopolski 2019, 1, 62–67. [Google Scholar]
- Hemp Production in the UE. Available online: https://agriculture.ec.europa.eu/farming/crop-productions-and-plant-based-products/hemp_en (accessed on 15 February 2024).
- Kursa, W.; Jamiołkowska, A.; Skwaryło-Bednarz, B.; Kowalski, R.; Wyrostek, J.; Patkowska, E.; Kopacki, M. In vitro efficacy of herbal plant extracts on some phytopathogenic fungi. Acta Sci. Pol.-Hortoru. 2022, 21, 79–90. [Google Scholar] [CrossRef]
- Al Khoury, A.; Sleiman, R.; Atoui, A.; Hindieh, P.; Maroun, R.G.; Bailly, J.D.; El Khoury, A. Antifungal and anti-aflatoxigenic properties of organs of Cannabis sativa L.: Relation to phenolic content and antioxidant capacities. Arch. Microbiol. 2021, 203, 4485–4492. [Google Scholar] [CrossRef]
- Isidore, E.; Karim, H.; Ioannou, I.; Isidore, E.; Karim, H.; Ioannou, I. Extraction of phenolic compounds and terpenes from Cannabis sativa L. by-products: From conventional to intensified processes. Antioxidants 2021, 10, 942. [Google Scholar] [CrossRef] [PubMed]
- Atalay, S.; Jarocka-Karpowicz, I.; Skrzydlewska, E. Antioxidative and Anti-Inflammatory Properties of Cannabidiol. Antioxidants 2020, 9, 21. [Google Scholar] [CrossRef] [PubMed]
- Kopustinskiene, D.M.; Masteikova, R.; Lazauskas, R.; Bernatoniene, J. Cannabis sativa L. Bioactive compounds and their protective role in oxidative stress and inflammation. Antioxidants 2022, 11, 660. [Google Scholar] [CrossRef] [PubMed]
- Fathordoobady, F.; Singh, A.; Kitts, D.D.; Pratap Singh, A. Hemp (Cannabis sativa L.) extract: Anti-microbial Properties, Methods of Extraction and Potential Oral Delivery. Food Rev. Int. 2019, 35, 664–684. [Google Scholar] [CrossRef]
- Glivar, T.; Eržen, J.; Kreft, S.; Zagožen, M.; Čerenak, A.; Čeh, B.; Benković, E.T. Cannabinoid content in industrial hemp (Cannabis sativa L.) varieties grown in Slovenia. Ind. Crop. Prod. 2020, 145, 112082. [Google Scholar] [CrossRef]
- García-Tejero, I.F.; Zuazo, V.D.; Sánchez-Carnenero, C.; Hernández, A.; Ferreiro-Vera, C.; Casano, S. Seeking suitable agronomical practices for industrial hemp (Cannabis sativa L.) cultivation for biomedical applications. Ind. Crop. Prod. 2019, 139, 111524. [Google Scholar] [CrossRef]
- Moreno, T.; Montanes, F.; Tallon, S.J.; Fenton, T.; King, J.W. Extraction of cannabinoids from hemp (Cannabis sativa L.) using high pressure solvents: An overview of different processing options. J. Supercrit. Fluids 2020, 161, 104850. [Google Scholar] [CrossRef]
- Izzo, A.A.; Borrelli, F.; Capasso, R.; Di Marzo, V.; Mechoulam, R. Non-psychotropic plant cannabinoids: New therapeutic opportunities from an ancient herb. Trends Pharmacol. Sci. 2009, 30, 515–527. [Google Scholar] [CrossRef] [PubMed]
- Mańkowska, G.; Luwańska, A.; Wielgus, K.; Bocianowski, J. Ocena zawartości kannabinoidów wybranych odmian konopi Cannabis sativa L. Biul. Inst. Hod. Aklim. Roślin 2015, 277, 79–86. [Google Scholar] [CrossRef]
- Hong, H.; Sloan, L.; Saxena, D.; Scott, D.A. The Antimicrobial Properties of Cannabis and Cannabis-Derived Compounds and Relevance to CB2-Targeted Neurodegenerative Therapeutics. Biomedicines 2022, 10, 1959. [Google Scholar] [CrossRef] [PubMed]
- Pasquali, F.; Schinzari, M.; Lucchi, A.; Mandrioli, M.; Toschi, T.G.; De Cesare, A.; Manfreda, G. Preliminary data on the antimicrobial effect of Cannabis sativa L. variety Futura 75 against food-borne pathogens in vitro as well as against naturally occurring microbial populations on minced meat during storage. Ital. J. Food Saf. 2020, 9, 8581. [Google Scholar] [CrossRef] [PubMed]
- Esra, M.M.A.; Aisha, Z.I.A.; Salwa, M.E.K.; Umelkheir, M.A.G. Antimicrobial Activity of Cannabis sativa L. Chin. Med. 2012, 3, 61–64. [Google Scholar] [CrossRef]
- Khan, I.H.; Javaid, A. Antifungal Activity of leaf extract of Cannabis Sativa against Aspergillus flavipes. Pakistan J. Weed Sci. Res. 2020, 26, 447–453. [Google Scholar] [CrossRef]
- Nazzaro, F.; Fratianni, F.; Coppola, R.; De Feo, V. Essential oils and antifungal activity. Pharmaceuticals 2017, 10, 86. [Google Scholar] [CrossRef] [PubMed]
- Khan, I.H.; Javaid, A.; Shad, N. Comparative efficacy of organic solvent fractions of leaf extract of hemp against Aspergillus versicolor. Pakistan J. Weed Sci. Res. 2021, 27, 101–108. [Google Scholar] [CrossRef]
- Tapwal, A.; Garg, S.; Gautam, N.; Kumar, R. In Vitro antifungal potency of plant extracts against five phytopathogens. Braz. Arch. Biol. Technol. 2011, 54, 1093–1098. [Google Scholar] [CrossRef]
Disclaimer/Publisher’s Note: The statements, opinions and data contained in all publications are solely those of the individual author(s) and contributor(s) and not of MDPI and/or the editor(s). MDPI and/or the editor(s) disclaim responsibility for any injury to people or property resulting from any ideas, methods, instructions or products referred to in the content. |
© 2024 by the authors. Licensee MDPI, Basel, Switzerland. This article is an open access article distributed under the terms and conditions of the Creative Commons Attribution (CC BY) license (https://creativecommons.org/licenses/by/4.0/).








